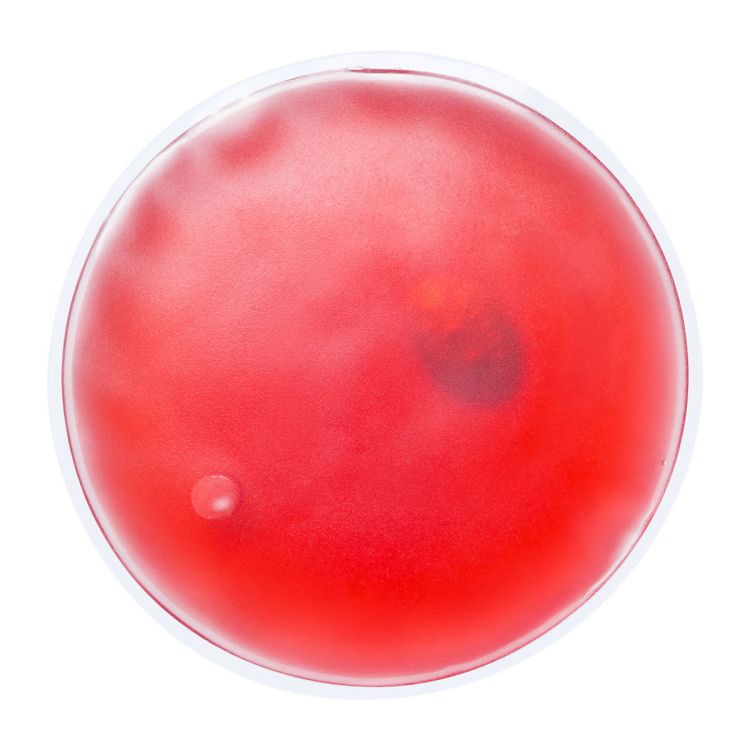

RELIEF - chaufferette
HG781012
Chaufferette transparente réutilisable avec gel coloré.
Taille du produit: ø100×10 mm
Taille du produit: ø100×10 mm
| QtyQuantité | 1 | 150 | 300 | 600 | 1500 | 3000 | 6000 |
| Prix | 0.77 | 0.70 | 0.64 | 0.58 | 0.53 | 0.50 | 0.47 |

NOUVEAU ICI? Obtenez 10€ de réduction !
En vous inscrivant vous recevrez le code par email.
Quantité conseillée: 200 pièces
Vous pouvez également acheter cet article en plus petites quantités avec un petit supplément.
Brouillon graphique gratuit après la commande
Des modifications peuvent être requises et nous ne procéderons à l'impression qu'après votre confirmation. Si le projet graphique ne répond pas à vos attentes, nous procéderons au remboursement intégral de votre commande.
Délais d'expédition estimés
Livraison gratuite dans toute l'Europe
Date de commande
Samedi 30 mai
Expédition d'articles non imprimés
Mardi 2 juin
Expédition d'articles imprimés
Ven. 12 juin - Mar. 16 juin
Disponibilité totale
Sélectionnez la couleur pour afficher la disponibilité spécifique